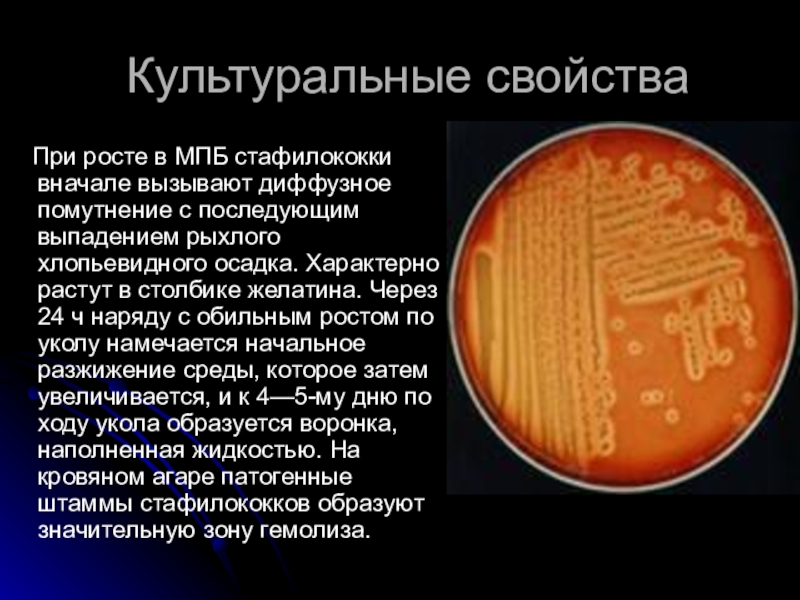
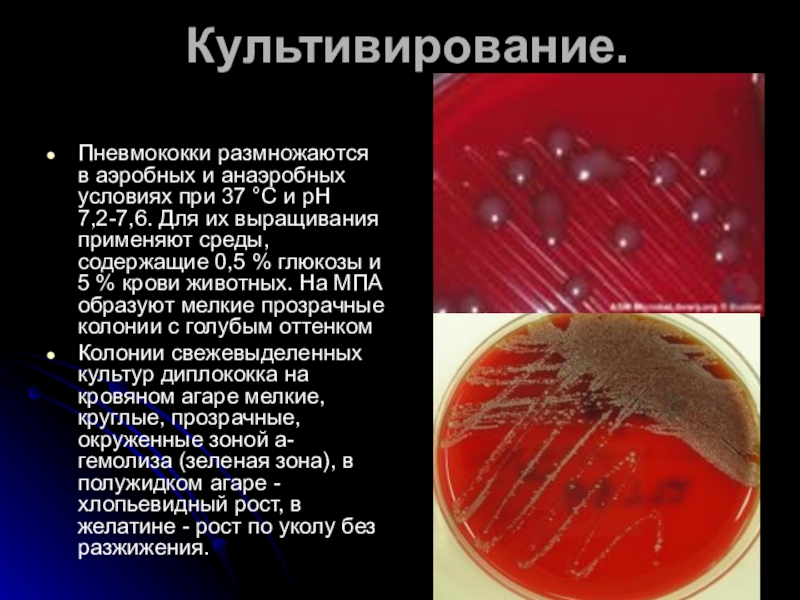

Слайд 1Частная микробиология
План изучения инфекционных заболеваний.
Видовое латинское название возбудителя.
Морфология (Гр+/-; палочки/кокки;
споры, жгутики, капсула?).
Культуральные св-ва ( на каких питательных средах растет,
какие формы колоний образует: S/R?)
Антигенная структура.
Факторы патогенности.
Источник инфекции.
Пути передачи.
Патогенез.
Иммунитет.
Профилактика.
Лечение.
Диагностика.
Слайд 2ПАТОГЕННЫЕ КОККИ
Кокки — широко распространенная в природе
группа шаровидных сапрофитных и реже патогенных бактерий. Они относятся к
семейству Micrococcaceae.
Патогенными для животных являются главным образом бактерии родов Staphylococcus и Streptococcus. Обитают они на коже и слизистых оболочках дыхательных, пищеварительных и мочеполовых путей. Многие кокки — представители нормальной микрофлоры организма.
Слайд 3Стафилококки
Стафилококки — сферические грамположительные неподвижные аспорогенные бактерии. Открыты в 1880
г. Л. Пастером.
К настоящему времени описано 28 видов стафилококков, изолированных
от животных и человека. Наибольший интерес представляют три вида: золотистый стафилококк (S.aureus) – патогенный; эпидермальный (S. epidermidis) – условно-патогенный; сапрофитический (S. saprophyticus) – непатогенный
Стафилококки имеют важное значение в инфекционной патологии животных: практически любой орган и любая ткань могут быть поражены этими микробами. Они вызывают фурункулы, абсцессы, остеомиелиты, маститы, эндометриты, бронхиты, пневмонии, менингиты, пиемии и септицемии, энтероколиты, пищевые токсикозы, стафилококкоз птиц.
Слайд 4Морфология
Стафилококки представляют собой круглые клетки (кокки) диаметром 0,8–1 мкм, располагающиеся
в виде скоплений, напоминающих виноградные грозди, иногда располагаются в виде
коротких цепочек или парными и одиночными клетками. Они неподвижны, спор и капсул (!) не образуют, красятся всеми анилиновыми красителями, грамположительны.
Слайд 5Культуральные свойства
Факультативные анаэробы. Хорошо растут на универсальных питательных средах при
температуре 35—40 °С (возможен рост в интервале 6,5—46 °С), оптимум
рН 7,0—7,5. Добавление к питательной среде глюкозы или крови ускоряет рост стафилококков. Характерное свойство большинства штаммов — способность расти в присутствии 15 % хлорида натрия или 40 % желчи. На МПА образуют круглые, слегка возвышающиеся над поверхностью агара колонии с ровными краями диаметром 2—5 мм.
Слайд 6Культуральные свойства
Колонии могут быть окрашенными. S.aureus синтезирует золотистый или оранжевый
пигмент; S.epidermidis, как правило, синтезирует пигмент белого или желтого цвета;
у большинства штаммов S.saprophyticus пигмент отсутствует.
Слайд 7Культуральные свойства
При росте в МПБ стафилококки вначале вызывают
диффузное помутнение с последующим выпадением рыхлого хлопьевидного осадка. Характерно растут
в столбике желатина. Через 24 ч наряду с обильным ростом по уколу намечается начальное разжижение среды, которое затем увеличивается, и к 4—5-му дню по ходу укола образуется воронка, наполненная жидкостью. На кровяном агаре патогенные штаммы стафилококков образуют значительную зону гемолиза.
Слайд 8Биохимические свойства.
Стафилококки ферментируют углеводы с образованием кислоты без газа.
Выделяют аммиак и сероводород, не образуют индол. Свертывают и пептонизируют
молоко, разжижают желатин, иногда свернутую сыворотку крови.
Слайд 9Токсинообразование.
Патогенные стафилококки секретируют высокоактивные экзотоксины и ферменты. Среди экзотоксинов выделяют
:
Гистотоксин – летальный (смерть у подопытных животных через 15 мин
В/в введения) и дерматонекротический (зона некроза при в/кожн введении кроликам.
Гемотоксин вызывает лизис эритроцитов
Лейкоцидин вызывает дегрануляцию и разрушение лейкоцитов.
Энтеротоксины — термостабильные, образуются при размножении в продуктах питания (молоко, сливки, творог и др.), кишечнике. Устойчивы к действию пищеварительных ферментов. Известно шесть антигенных вариантов. Энтеротоксины вызывают пищевые токсикозы, к ним чувствительны кошки, особенно котята, и щенки собак.
К факторам патогенности стафилококков также относятся ферменты коагулаза, гиалуронидаза, фибринолизин, ДНК-аза, лецитиназа и др. Коагулаза — бактериальная протеиназа, свертывающая плазму крови животных. Наличие коагулазы является одним из наиболее важных и постоянных критериев патогенности стафилококков.
Слайд 10Антигенная структура.
У стафилококков лучше всего изучены антигены клеточной стенки:
пептидогликан, тейхоевые кислоты и белок А. Пептидогликан — общий видовой
для стафилококков антиген. Тейхоевые кислоты —видоспецифические полисахаридные антигены. S.aureus содержит полисахарид A, S.epidermidis — полисахарид В. Протеин А обнаружен у золотистого стафилококка. Это низкомолскулярный белок, имеющий свойство соединяться с Fc-фрагмснтами IgG млекопитающих. Штаммы, продуцирующие большое количество белка А, обладают более высокой резистентностью к фагоцитозу.
Слайд 11Устойчивость.
Стафилококки относительно резистентные микроорганизмы. Прямые солнечные лучи убивают их
только через несколько часов. В пыли сохраняются 50—100 дней, в
высушенном гное — более 200 дней, в бульонной культуре — 3—4 мес, при 70°С погибают через 1 ч, при 85 °С — через 30 мин, при 100 °С — за несколько секунд. Из дезинфектантов 1 %-ный раствор формалина и 2 %-ный раствор гидроокиси натрия убивают их в течение 1 ч, 1 %-ный раствор хлорамина — через 2—5 мин. Стафилококки обладают высокой чувствительностью к бриллиантовому зеленому.
Слайд 12Патогенность.
Основная роль в инфекционной патологии животных и человека принадлежит
S. aureus. Пигментообразование и расщепление углеводов не могут служить критерием
патогенности стафилококков. Главнейшими факторами, определяющими патогенность этих бактерий, является способность продуцировать экзотоксины и ферменты коагулазу, фибринолизин и гиалуронидазу.
К стафилококкам чувствительны лошади, крупный и мелкий рогатый скот, свиньи, утки, гуси, индейки, куры, из лабораторных животных — кролики, белые мыши, котята. При внутрикожном введении кроликам культуры патогенных стафилококков развивается воспаление и затем некроз кожи, при внутривенной инъекции фильтрата культур у кроликов наступает острое отравление и гибель через несколько минут.
Слайд 13Патогенез.
В организм стафилококки проникают через поврежденную кожу
и слизистые оболочки, энтеротоксины — с пищей.
Стафилококковые инфекции
чаще развиваются и тяжелее протекают в условиях снижения естественной резистентности организма и при иммунодефицитных состояниях. В патогенезе стафилококковых процессов ведущая роль принадлежит экзотоксинам и ферментам патогенности. Важное значение может иметь и аллергия. Все эти факторы вместе и определяют, возникнут ли локальные гнойно-воспалительные очаги, системные заболевания внутренних органов, сепсис или пищевые токсикозы.
Слайд 14Иммунитет.
У здоровых животных имеется естественная резистентность
к стафилококковой инфекции. Она обусловлена барьерной функцией кожи, слизистых оболочек,
фагоцитозом и наличием специфических антител, синтезированных в результате скрытой иммунизации. Иммунитет при стафилококковых инфекциях преимущественно антитоксический, слабой напряженности и непродолжительный. Поэтому не исключены частые рецидивы. Тем не менее высокие титры антитоксинов в крови животных повышают их устойчивость к повторным заболеваниям. Антитоксины не только нейтрализуют экзотоксины, но и обусловливают быструю мобилизацию фагоцитов. Стафилококки также индуцируют гиперчувствительность замедленного типа.
Слайд 15Биопрепараты.
Антибиотики широкого спектра действия
Очищенный адсорбированный стафилококковый анатоксин
Аутовакцина —
прогретый при 70—75 °С смыв агаровой культуры стафилококка, выделенного из
организма больного животного.
Иногда местно применяют стафилококковый бактериофаг.
Слайд 16Стрептококки
Патогенные стрептококки заселяют слизистые оболочки, кожу и проявляют свою патогенность
при снижении общей резистентности организма животного или отдельных тканей (при
травме, ожоге и т. п.).
В естественных условиях стрептококки являются возбудителями заболеваний у крупного рогатого скота и лошадей, а также нагноительных процессов. У поросят и птиц вызывают септическое заболевание - стрептококкоз. Иногда обусловливают осложнения вирусных и бактериальных инфекций.
Слайд 17Антигенная структура
Современная классификация основывается на опре-делении антигенной структуры стрептококков, позволяющей
подразделить все стрептококки на 17 серологических групп, обозначаемых латинскими буквами
в порядке алфавита. Практический интерес представляют серогруппы А, В, С, D, E, F. Группа А - возбудители большого числа инфекций у человека; группа В - возбудители мастита у коров; группы В, С, D, Е - возбудители инфекций у животных разных видов. Антигеном, который позволяет разделить стрептококки на серогруппы, является полисахарид (С-вещество), входящий в состав клеточной стенки стрептококков.
Слайд 18Возбудитель мыта.
Streptococcus equi открыл Щютц в 1888г. Мыт - контагиозное
заболевание преимущественно молодняка цельнокопытных животных (до двух лет), характеризующееся катарально-гнойным
воспалением слизистой оболочки верхних дыхательных путей, подчелюстных и заглоточных лимфатических узлов.
Слайд 19Морфология.
Мазки окрашивают по Граму и Романовскому-- Гимзе. Для Str. equi
в гное (мытный абсцесс, носовое истечение) характерно расположение длинными цепочками
сплющенных в поперечнике кокков, в мазках из агаровой и бульонной культур возбудитель имеет вид коротких цепочек, иногда по два кокка. Капсул и спор не образует. Неподвижен. Величина кокков 0,6 - 1,0 мкм. Грамположительный.
Слайд 20Культивирование.
Для выделения чистой культуры проводят посев на сывороточно-глюкозный агар
(на обычных средах не растет). Через 24 ч на агаре
мытный стрептококк образует мелкие, просвечивающиеся, похожие на капельки росы колонии. Характерно слияние колоний между собой.
На кровяном агаре рост в виде мелких колоний с зоной в-гемолиза. На свернутой кровяной сыворотке Str. equi образует стекловидные сероватые колонии. В сывороточном бульоне и среде Китта-Тароцци отмечается рост мелкими крупинками, выстила-ющими стенки и дно пробирки, бульон остается прозрачным.
Слайд 21Биохимические свойства.
Мытный стрептококк не свертывает простое молоко, лакмусовое и метиленовое
молоко не обесцвечивает (не редуцирует), не ферментирует лактозу, сорбит, маннит.
От-сутствие ферментации названных углеводов позволяет дифференцировать мытный стрептококк от гноеродного (Str. pyogenes), который сбраживает лактозу, свертывает молоко, редуцирует метиленовую синь.
Слайд 22Токсинообразование.
Выражено слабо.
Антигенная структура.
Str. equi относят к серогруппе С. Они содержат
полисахарид С, синтезируют экстрацеллюларные антигены (токсины), О - стрептолизин (белок)
и S - стрептолизин (липидно-протеиновый комплекс). Все они способны вызывать разрушение эритроцитов.
Слайд 23Устойчивость.
Во влажном гное сохраняется до 6 мес, в навозе -
один месяц. При нагревании до 70 °С погибает в течение
1 ч, при 85°С - за 30 мин. В качестве дезинфектантов используют 1 %-ный раствор формалина, 2 %-ный раствор гидроокиси натрия при экспозиции 10-30 мин
Слайд 24Иммунитет и биопрепараты.
Животные, переболевшие мытом, приобретают стойкий иммунитет (чаще всего
пожизненный). Вакцины из убитых культур стрептококков не вызывают иммунитета. Не
получила применения и противомытная сыворотка ввиду ее дороговизны.
В качестве специфического средства лечения применяют анти-вирус, который представляет собой фильтрат 20-суточной бульонной культуры Str. equi, изготовленный из местных штаммов стрептококка. Больным мытом животным препарат вводят подкожно в области верхней трети шеи в дозе 50-100 мл, в зависимости от массы и возраста животного. Инъекции лучше делать в нескольких местах. При отсутствии заметного эффекта антивирус вводят повторно через сутки или двое. Препарат можно применять для компрессов и промывания абсцессов. При гиперплазии подчелюстных и околоушных лимфатических узлов антивирус вводят подкожно в области этих узлов.
Слайд 25Возбудитель мастита.
Str. agalactiae - мелкие, диаметром 0,5-1 мкм, чуть сплющенные
или овальные кокки, располагающиеся длинными цепочками (несколькими десятками кокков). В
мазках из культур, выросших на плотных питательных средах, маститный стрептококк образует короткие цепочки. Спор и капсул не образует. Хорошо окрашивается всеми анилиновыми красками, грамположителен
Слайд 26Культивирование.
Маститный стрептококк - аэроб. На обычных питательных средах растет слабо.
Хорошо культивируется на средах с добавлением дефибринированной крови или кровяной
сыворотки. В сывороточном МПБ растет в виде мелкозернистого осадка, при этом среда остается прозрачной. На кровяном МПА образует мелкие (точечные) блестящие сероватые колонии, окруженные зоной ге-молиза (гемолиз в-типа).
Слайд 27Биохимические свойства.
Маститный стрептококк не разжижает мясо-пептонный желатин и свернутую сыворотку,
не обесцвечивает метиленовое молоко, лакмусовое молоко изменяет частично. Ферментирует с
образованием кислоты глюкозу, лактозу, сахарозу, мальтозу, салицин.
Для выяснения потенциальной гемолитической активности стрептококков мастита используют CAMP (КАМП) - метод, получивший свое название по первоначальным буквам фамилий австралийских исследователей: Кристи, Аткинс и Мунх-Петерсон. Метод основан на усилении гемолитической активности стрептококка группы В в зоне, близкой к полосе гемолиза стафилококка на кровяном агаре; гемолитические, но. утратившие или снизившие гемолитическую активность штаммы агалактийного стрептококка образуют заметную зону гемолиза вблизи стафилококка.
Слайд 28Токсинообразование.
Маститный стрептококк продуцирует токсины: эритротоксин, гемолизин, некротоксин, лейкоцидин
и ферменты:
фибринолизин и гиалуронидазу.
Антигенная структура.
Str. agalactiae относят к серогруппе В.
Устойчивость.
В высушенном
гнойном экссудате сохраняется 2-3 мес. При нагревании до 85 °С погибает за 30 мин. Замораживание консервирует его.
Иммунитет.
Обусловлен антитоксическими и антибактериаль-ными факторами.
Биопрепараты.
Их нет. Для лечения используют антибиотики и сульфаниламиды, которые вводят через канал соска в молочную цистерну.
Слайд 29Возбудитель диплококковой инфекции.
Str. pneumoniae был выделен в 1871 г. Л.
Пастером из слюны ребенка, погибшего от бешенства. Пневмококки широко распространены
в природе. У здоровых животных обнаруживаются на слизистых оболочках дыхательных путей, пищеварительного тракта, половых органов. Болезнь характеризуется септицемией, поражением легких (лобулярная пневмония). У коров, овец, свиней, коз, лошадей вследствие нарушения зоотехнических норм содержания и неполноценного кормления в период беременности после родов скрытое носительство пневмококков переходит в клинически выраженное заболевание - развиваются маститы и эндометриты.
Слайд 30Морфология.
В мазках из патологического материала стрептококки овальной формы и располагаются
попарно или короткими цепочками. Размеры клеток 0,8-1,25 мкм. Неподвижны. Спор
не образуют. В организме пневмококки образуют хорошо выраженную капсулу, которая утрачивается при культивировании на искусственных питательных средах, но сохраняется на средах с сывороткой или кровью.
Слайд 31Культивирование.
Пневмококки размножаются в аэробных и анаэробных условиях при 37 °С
и рН 7,2-7,6. Для их выращивания применяют среды, содержащие 0,5
% глюкозы и 5 % крови животных. На МПА образуют мелкие прозрачные колонии с голубым оттенком
Колонии свежевыделенных культур диплококка на кровяном агаре мелкие, круглые, прозрачные, окруженные зоной а-гемолиза (зеленая зона), в полужидком агаре - хлопьевидный рост, в желатине - рост по уколу без разжижения.
Слайд 32Биохимические свойства.
Ферментируют с образованием кислоты глюкозу, лактозу, сахарозу, маннит; не
ферментируют арабинозу и дульцит; не образуют пигмента и индола.
Токсинообразование.
На полужидком
агаре с кровью и мальтозой продуцируют токсин, вызывающий смертельное отравление котят при пероральном введении.
Антигенная структура.
Внутри вида Str. pneumoniae имеются 84 серовара, агглютинирующихся только соответствующими типовыми сыворотками.
Устойчивость.
Диплококк мало устойчив. Нагревание при 55 °С вызывает гибель культуры через 10 мин. Во внешней среде погибает в течение 3--4 нед. В качестве дезинфектантов используют формалин, гидроокись натрия, известь.
Слайд 33Иммунитет
Сопровождается скрытым носительством диплококков в организме животных.
Биопрепараты.
Для специфической профилактики диплококковой
инфекции используют полужидкую формолвакцину, противо-диплококковую сыворотку, поливалентную формолквасцовую вакцину против
сальмонеллеза, пастереллеза и диплококкоза поросят.
А/б терапия.